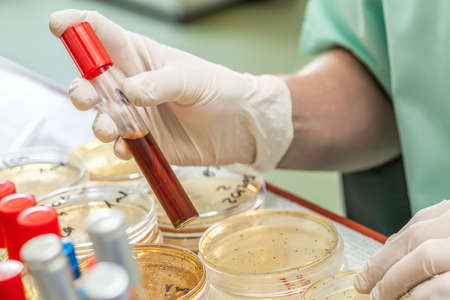
chemist at work in lab during tests with liquid substanceの写真素材

写真素材 - chemist at work in lab during tests with liquid substance
作品情報
chemist at work in lab during tests with liquid substance
- ID:22100150
- 作品種別:写真
- 作者名:Katarzyna Białasiewicz
キーワード
- academic
- academical
- accomplishment
- achievement
- analyse
- analysis
- apparatus
- biochemical
- biochemistry
- biology
- biotope
- blood
- chemical
- chemistry
- colourful
- dangerous
- discovery
- drug
- education
- educational
- educative
- glass
- health
- healthy
- lab
- labor
- laboratory
- liquid
- medical
- medicine
- petri dish
- progress
- reaction
- research
- science
- scientific
- scientist
- serum
- stand
- substance
- technology
- test
- testing
- toxin
- tube
- tubes
- test tube
類似作品
I might make so...
Portrait of a y...
Chemical labora...
Research, exper...
little schoolbo...
A scientist met...
Group of dedica...
tired scientist...
Group of dedica...
young gifted ma...
Scientist pipet...
A man stands in...
For future expe...
Young handsome ...
Scientist in Me...
Male Scientist ...
professional ch...
Female Scientis...
Wearing white c...
Surprised resea...
Young male chem...
Thoughtful fema...
Scientist worki...
medical marijua...
Young clinician...
Young male chem...
Man in laborato...
Laboratory assi...
Brunette lookin...
Young researche...
A focused male ...
Chemist working...
Life science re...
Young Scientist...
Coronavirus COV...
Lab chemist wor...
Doctor at farma...
Portrait of pre...
Double exposure...
Chemical labora...
A researcher in...
scientist worki...
A dedicated fem...
Blood test in t...
Scientist pipet...
Female scientis...
professional he...
Organizing all ...
Chemical labora...